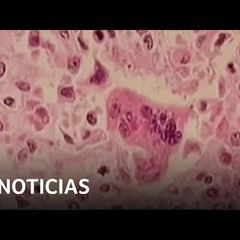

| |
Video News Review at 11 a.m. Daily
Current Video News:
https://www.inoreader.com/stream/user/1006407045/tag/YouTube%20subscriptions/view/html?cs=m&sb=y
Selected Articles Review From The News And Times -
https://thenewsandtimes.blogspot.com/
Current Selected Articles: https://www.inoreader.com/stream/user/1006407045/tag/user-favorites/view/html
All Current Articles: https://www.inoreader.com/stream/user/1006407045/tag/all-articles/view/html |
|
 | Nadler: Special counsel Hur's report was 'total exoneration' of Biden |
| Rep. Jerry nadler, D-N.Y., delivered his opening statement at a hearing with special counsel Robert Hur.... |
 NBC News NBC News | 1m | |
|
 | Sexual orientation and gender identity can be discussed in Florida schools after... |
| Florida will now allow teachers and students to speak about sexual orientation and gender identity in... |
 NBC News NBC News | 1m | |
|
 | London Mayor Sadiq Khan demands PM call out comments by Tory donor |
| London Mayor Sadiq Khan has criticised the Conservative Party and Rishi Sunak for not labelling reported... |
 Sky News Sky News | 2m | |
|
 | Russia Presidential elections: Russia spy service accuses US of trying to meddle... |
| With elections next month, who are Vladimir Putin's challengers and what chance to they stand against... |
| |
|
 | US: Biden-Trump to clinch party nominations, four states to hold primaries | World... |
| Former US President and Republican Presidential Candidate Donald Trump hit out at US President Joe Biden... |
| |
|
 | US threat report: Hamas a threat to Israel for years | Latest English News | WION |
| An annual threat assessment compiling US intelligence warned that Israel will be challenged by Hamas... |
| |
|
 | US report: Israel likely to face Hamas resistance 'for years to come' | Latest English... |
| An annual threat assessment compiling US intelligence warned that Israel will be challenged by Hamas... |
| |
|
 | On Ukraine's Front Lines, Ammunition Dwindling |
| Ukrainian front-line forces are suffering from a worrying shortage of ammunition. Repeated delays in... |
 VOA News VOA News | 3m | |
|
 | 💥ЧЕРНИК: Могли вдарити ЯДЕРКОЮ по Львівщині. США готувалися до ЯДЕРНОГО УДАРУ по... |
| Наприкінці 2022 року США розпочали серйозну підготовку до того, що Росія потенційно може завдати удару... |
 24 Канал 24 Канал | 3m | |
|
 | 😮Страшний сон Путіна став реальністю! Трибунал в Гаазі очолила... Бункер ВЖЕ тремтить |
| Судді Міжнародного кримінального суду 11 березня на пленарному засіданні обрали нову голову для свого... |
 24 Канал 24 Канал | 3m | |
|
 | ШЕЙТЕЛЬМАН: Папа Римский РАБОТАЕТ на РОССИЮ / В ЕС все ВОЗМУЩЕНЫ: есть реакция БЕРБОК |
| Папа Римский Франциск заявил, что для Украины было бы "смелым поступком" поднять "белый флаг" и начать... |
 24 Канал 24 Канал | 3m | |
|
 | Бои в Белгородской и Курской областях: россияне, воюющие за Украину, прорвались на... |
| Представители легиона "Свобода России", "Русского добровольческого корпуса" (РДК) и Сибирского батальона,... |
 Настоящее Время Настоящее Время | 5m | |
|
 | Военный эксперт о вторжении диверсантов в российские города |
| Сегодня утром сообщили, что украинские военные подразделения — Легион «Свобода России», «Русский добровольческий... |
 Штаб Навального Штаб Навального | 5m | |
|
 | Andrew and Tristan Tate detained in Romania on British arrest warrant |
| Social media influencer Andrew Tate and his brother Tristan have been arrested in Romania over UK sex... |
 The Telegraph The Telegraph | 6m | |
|
 | Fire reported at Russian oil refineries after mass Ukrainian drone attack |
| A fire has broken out at an oil refinery in the Russian city of Oryol as part of a collection of drone... |
 euronews (in English) euronews (in English) | 8m | |
|
 | German train drivers strike coincides with Lufthansa cabin crew walkout |
| The train driver GDL union is demanding for working hours to be reduced from 38 to 35 hours per week... |
 euronews (in English) euronews (in English) | 8m | |
|
 | 'Work together to save the country': Haiti violence spirals as PM resigns • FRANCE... |
| Haiti's unelected prime minister, Ariel Henry, will step down once a transition council and temporary... |
 FRANCE 24 English FRANCE 24 English | 9m | |
|
 | 'France is not the only country to have concluded a bilateral agreement with Ukraine'... |
| Reporting from the French Parliament, FRANCE 24 reporter Clovis Casali said France is not the only country... |
 FRANCE 24 English FRANCE 24 English | 9m | |
|
 | Biden propone incluir 4,700 millones de dólares para seguridad en la frontera en... |
| El fondo de contingencia permitiría al Departamento de Seguridad Nacional acceder a fondos cuando la... |
 NOTICIAS TELEMUNDO NOTICIAS TELEMUNDO | 9m | |
|
 | El albergue de migrantes Casa Anunciación podrá seguir operando tras fallo de un... |
| La demanda del fiscal general de Texas contra el refugio alega que facilita la entrada irregular de personas... |
 NOTICIAS TELEMUNDO NOTICIAS TELEMUNDO | 9m | |
|
 | В Курске бездомный пёс ездил на маршрутках на обед |
| Бездомный пёс Маратик из Курска нашёл свою семью. А до этого бесплатно катался на маршрутках, удивляя... |
 Комсомольская Правда Комсомольская Правда | 10m | |
|
 | Trump Supporter Predicts Trump Will Receive 90% of the Popular Vote #shorts |
| Trump Supporter Predicts Trump Will Receive 90% of the Popular Vote --- Become a Member: https://www.davidpakman.com/membership... |
 David Pakman Show David Pakman Show | 10m | |
|
 | Andrew & Tristan Tate Detained In Romania Over UK Sex Offence Charges |
| Influencer Andrew Tate and his brother Tristan have been arrested in Romania over UK sex offence charges,... |
 Hindustan Times Hindustan Times | 11m | |
|
 | Bishop Lamor Miller-Whitehead found guilty of wire fraud, extortion | NBC New York |
| A Brooklyn preacher known for his flashy lifestyle and who boasted of his friendship with New York City's... |
 NBC New York NBC New York | 11m | |
|
 | Соцсети об Оскаре для украинского фильма о войне |
| Церемония вручения "Оскара" традиционно обсуждается в соцсетях. Скорее всего, блогерам хватило бы пищи... |
 Радио Свобода Радио Свобода | 11m | |
|
 | Инициатива Макрона: декларация или намерения? |
| Ссылка на источник - https://www.svoboda.org/a/32857460.html Почему в последние месяцы позиция Эммануэля... |
 Радио Свобода Радио Свобода | 11m | |
|
 | Крушение Ил-76 и атаки беспилотников в 10 регионах России |
| Самолет Ил-76 потерпел крушение в Ивановской области, погибли 15 человек. И это уже второе крушение военно-транспортного... |
 Радио Свобода Радио Свобода | 11m | |
|
 | En video: renuncia el primer ministro de Haití |
| Ariel Henry anunció su dimisión bajo presión internacional y en plena ola de violencia que enfrenta el... |
 primerahoravideos primerahoravideos | 13m | |
|
 | В Румынии задержан скандальный блогер Эндрю Тейт |
| Эндрю Тейт и его брат Тристан задержаны в Румынии по ордеру на арест, выданному Лондоном. Братьев Тейт... |
 euronews (на русском) euronews (на русском) | 14m | |
|
 | 'They Rely On Economical Fairy Dust': Sheldon Whitehouse Blasts GOP Budget, Praises... |
| At a Senate Budget Committee hearing on Tuesday, Sen. Sheldon Whitehouse (D-RI) spoke about the proposed... |
 Forbes Under 30 Forbes Under 30 | 16m | |
|
 | Scott Perry Points Out FEMA Is Being Asked To Help With Issues 'Completely Unrelated... |
| During a House Transportation & Infrastructure Committee hearing on Tuesday, Rep. Scott Perry (R-PA)... |
 Forbes Under 30 Forbes Under 30 | 16m | |
|
 | Inflation Comes In Higher Than Expected For Fourth Straight Month |
| Inflation was worse than anticipated in February, even as underlying metrics show signs of progress in... |
 Forbes Under 30 Forbes Under 30 | 16m | |
|
 | BREAKING NEWS: Jim Jordan Plays Video Of Biden For Special Counsel Robert Hur To... |
| At today's House Judiciary Committee hearing, Rep. Jim Jordan (R-OH) played a video for Special Counsel... |
 Forbes Under 30 Forbes Under 30 | 16m | |
|
 | JUST IN: House Democrats Announce Border Security Task Force: 'We're Calling For... |
| Rep. Henry Cuellar (D-TX) led a press briefing on Tuesday with House Democrats to discuss border security.... |
 Forbes Under 30 Forbes Under 30 | 16m | |
|
 | Trump Vows To Free Jan. 6 Rioters As One Of His 'First Acts' If Reelected |
| Former President Donald Trump said Monday he intends to free imprisoned Jan. 6 rioters as one of his... |
 Forbes Under 30 Forbes Under 30 | 16m | |
|
 | CPI Report Reaction: Inflation Slightly Lower Than Expected, Though Still Elevated |
| Pagliara, the chairman and chief investment officer of CapWealth, joins "Forbes Newsroom" to discuss... |
 Forbes Under 30 Forbes Under 30 | 16m | |
|
 | Haiti's Prime Minister Ariel Henry resigns with unrest gripping country |
| Haitian Prime Minister Ariel Henry says he will step down once a transitional presidential council is... |
| |
|
 | ¿Cómo ver el eclipse solar total de 2024? Sigue estas recomendaciones |
| El lunes 8 de abril de 2024, un eclipse solar total cruzará América del Norte: pasará por México, Estados... |
 Univision Noticias Univision Noticias | 16m | |
|
 | 🏠💦 Autos, casas y carreteras bajo el agua por una tormenta. |
| Así queda la zona costera de Hampton Beach, en New Hampshire, luego de una tormenta invernal que trajo... |
 Univision Noticias Univision Noticias | 16m | |
|
 | CAA Updates | Citizenship Amendment Act Rules In India | Lok Sabha Elections | PM... |
| CAA Updates | Citizenship Amendment Act Rules In India | Lok Sabha Elections | PM Modi | News18 The... |
| |
|
 | Israel Vs Hezbollah News | Hezbollah, Israel Trade Fire On Lebanon's Border | N18V... |
| Israel Vs Hezbollah News | Hezbollah, Israel Trade Fire On Lebanon's Border | N18V | News18 The... |
| |
|
 | El Gobierno aprueba la fusión Orange-MásMóvil y afronta "de buena fe" la negociación... |
| El Consejo de Ministros ha dado el visto bueno a la fusión de Orange y MásMóvil, después de que el Gobierno... |
 Europa Press Europa Press | 18m | |
|
 | Ayuso defiende que la investigación fiscal a su pareja nada tiene que ver con la... |
| La presidenta de la Comunidad de Madrid, Isabel Díaz Ayuso, ha defendido este lunes que "la investigación... |
 Europa Press Europa Press | 18m | |
|
 | Roig (Mercadona) defiende que los gobiernos apoyen a las empresas: "Es la riqueza... |
| El presidente de Mercadona, Juan Roig, preguntado por el cambio de gobierno en la Comunitat Valenciana... |
 Europa Press Europa Press | 18m | |
|
 | Four astronauts from four countries return to Earth after six months in orbit |
| SpaceX Dragon capsule carrying four astronauts returns from the International Space Station and splashes... |
 Associated Press Associated Press | 18m | |
|
 | LIVE: U.S. State Department press briefing |
| State Department Spokesperson Matthew Miller briefs the media. #news #statedepartment #live #livestream |
 Associated Press Associated Press | 18m | |
|
 | SpaceX Crew-7 successfully splashes down off Florida | REUTERS |
| The four-member SpaceX Crew-7 completed their nearly six-month mission aboard the International Space... |
| |
|
 | Haiti's premier says he'll resign once a transitional council is created |
| Haitian Prime Minister Ariel Henry announced early Tuesday that he would resign once a transitional presidential... |
 New York Post New York Post | 19m | |
|
 | 🔴 LIVE: Special Counsel Robert Hur testifies in Biden's classified documents case |
| Special Counsel Robert Hur is set to testify before the House Judiciary Committee on Tuesday morning... |
 New York Post New York Post | 19m | |
|
 | Israel-Hamas war: Israeli govt. confirms American-Israeli soldier Itay Chein is dead... |
| A U.S.-Israeli citizen who was kidnapped on Oct. 7 while Hamas terrorists invaded southern Israel and... |
 FOX 10 Phoenix FOX 10 Phoenix | 20m | |
|
 | Haiti crisis explained, as prime minister steps down | Al Jazeera Newsfeed |
| Haiti's Prime Minister Ariel Henry has announced he is stepping down, after gangs threatened a civil... |
 Al Jazeera English Al Jazeera English | 20m | |
|
 | China claims "indisputable sovereignty" over South China Sea islands |
| Chinese Foreign Ministry spokesperson Wang Wenbin reaffirmed China's sovereignty over South China Sea... |
| |
|
 | DEUTSCHLAND: "Bundestag der unterschiedlichen Mehrheiten!" Streit um Taurus spaltet... |
| DEUTSCHLAND: "Bundestag der unterschiedlichen Mehrheiten!" Streit um Taurus spaltet Ampel SPD-Generalsekretär... |
| |
|
 | Улицкая — о России после выборов. Каспаров — об оппозиции без Навального. Трамп vs... |
| Новый выпуск Екатерины Котрикадзе. Начинаем эфир в 18.00 мск. В этом выпуске: Людмила Улицкая — о репрессиях... |
| |
|
 | Southwest Airlines cuts capacity, and rethinks 2024 financial forecast, citing Boeing... |
| CNBC's Phil LeBeau joins 'Squawk on the Street' with the latest news from Southwest Airlines. |
 CNBC Television CNBC Television | 21m | |
|
 | Sweden and Finland join Nato military exercises | BBC News |
| Sweden and Finland have joined the first test of Nato's new military plans in response to Russia's invasion... |
| |
|
 | Los hoteleros esperan una Semana Santa histórica |
| Madrid, 12 mar (EFE)(Imagen: Ángel Herrera).- El sector hotelero espera alcanzar unos números históricos... |
 AGENCIA EFE AGENCIA EFE | 22m | |
|
 | Billy D'Elia is Hoffa Squad? #MichaelFranzese #JimmyHoffa #MobStory |
| 🍷🍷 Cheers! Visit https://franzesewine.com to grab a bottle of high-quality wine Subscribe to "The... |
 Michael Franzese Michael Franzese | 22m | |
|
 | WATCH LIVE: Supreme Court Justices Sotomayor and Barrett on political polarization,... |
| On March 12, Supreme Court Justices Sonia Sotomayor and Amy Coney Barrett will address the Civic Learning... |
 PBS NewsHour PBS NewsHour | 23m | |
|
 | Former MLB star Darryl Strawberry recovering after heart attack |
| The former New York Mets and Yankees slugger suffered a heart attack Monday night near St. Louis. |
 CBS New York CBS New York | 24m | |
|
 | 'Netanyahu's Leadership In Jeopardy': U.S. Intel Report Makes Big Claim On War With... |
| A U.S. intelligence report has raised alarm bells for Israeli PM Benjamin Netanyahu amid the ongoing... |
 Hindustan Times Hindustan Times | 27m | |
|
 | Paris hotel rooms to be empty during Olympics as tourists stay away |
| The 33rd modern Olympiad opens in the French capital on 26 July 2024, closing on 11 August. While... |
 The Independent The Independent | 27m | |
|
 | Celine Dion surprises hockey team in dressing room |
| Celine Dion laughed and joked with hockey players in Las Vegas as she made a surprise locker room visit.... |
 The Independent The Independent | 27m | |
|
 | MPs leave Downing Street after Cabinet meeting |
| MPs leave Downing Street after a Cabinet meeting held by Rishi Sunak, the day after Lee Anderson moved... |
 The Independent The Independent | 27m | |
|
 | Российские повстанцы атаковали Белгород | В Иваново разбился Ил-76 с ценными военными... |
| На разведывательные БПЛА для 25й Отдельной воздушно-десантной бригады, которая держит Авдеевское направление... |
 Ivan Yakovina Ivan Yakovina | 30m | |
|
 | Classical Music that Feels Like Spring |
| |
 HALIDONMUSIC HALIDONMUSIC | 32m | |
|
 | Watch live: Humberside Police deliver an update after 34 bodies removed from funeral... |
| Watch live: Humberside Police deliver an update on funeral director probe Two people have been arrested... |
| |
|
 | Казахстан шокував рішенням про Україну! Путіну краще це не чути |
| Казахстан може почати надавати військову допомогу Україні, а саме підключитися до надання допомоги. За... |
| |
|
 | ЗСУ ПОПЕРЕДИЛИ українців! Нові ГАРЯЧІ напрямки ФРОНТУ: зафіксовано ВЕЛИКІ БОЙОВІ... |
| Протягом 11 березня на фронті було 72 бойових зіткнення з окупантами. Найсильніше росіяни атакують на... |
| |
|
 | Прямо зараз! Боєць легіону "Свобода Росії" звернувся до росіян / Генштаб РФ в СТУПОРІ... |
| Легіон "Свобода Росії", Російський добровольчий корпус та Сибірський батальйон зайшли на територію Росії.... |
| |
|
 | 🧐А як ви готуєтесь до літа? Діліться у коментарях #shorts |
| 24 Канал запускає подкасти! Шукайте нас на різних, зручних для вас платформах: https://linktr.ee/podcast24tv.ua |
| |
|
 | 🔥На РОСІЇ війна! Танки йдуть на КУРСЬК і БЄЛГОРОД, падають ЛІТАКИ | Карта БОЙОВИХ... |
| 00:00 – Наліт дронів на НПЗ і ТЕЦ на болотах 05:33 – Розбився військовий літак Іл-76 08:16 – Бої... |
| |
|
 | Пропагандист ОХЛОБИСТЫН в шоке от Донбасса #shorts |
| 24 Канал запускає подкасти! Шукайте нас на різних, зручних для вас платформах: https://linktr.ee/podcast24tv.ua |
| |
|
 | На Росії ТРИВОЖНО! Добровольці на ТАНКАХ пруть на РФ / Путіна чекає ПАНІЧНА АТАКА:... |
| Вранці 12 березня у телеграм-каналах з'явилася інформація про прорив кордону російськими добровольцями... |
| |
|
 | 🤯Літак Іл-76 ГОРИТЬ у повітрі. Операція на РФ набирає обертів | Головне від МУСІЄНКА... |
| Ведуча 24 Каналу Катерина Соляр @soliarqueen обговорить найактуальніші новини України та світу станом... |
| |
|
 | New NATO member Sweden joins drills as Russian threat looms | AFP |
| Tanks power across the Arctic landscape of northern Finland and Norway as NATO conducts its biggest drills... |
| |
|
 | India elections: Nayab Singh Saini takes oath as new Haryana Chief Minister | Race... |
| On Race to Power tonight, + India elections: Congress releases second list + Haryana's new Chief... |
| |
|
 | Russia-Ukraine war LIVE: Most deadly weapons in use by Russia's military in Ukraine... |
| Russia-Ukraine war live: Have a look at the new generations of weapons in which Russia says it is investing... |
| |
|
 | Sela Tunnel: China fumes as PM Modi inaugurates Sela Tunnel in Arunachal Pradesh... |
| Indian PM Modi inaugurated the world's longest bi-lane tunnel in the northeastern state of Arunachal... |
| |
|
 | Whatsapp Investment scam | Tech It Out Shorts |
| @tutejankit tells you about the latest WhatsApp scam. About Channel: WION The World is One... |
| |
|
 | Joe Biden LIVE: Robert Hur set to testify on Joe Biden's classified docs case as... |
| Joe Biden LIVE: Robert Hur set to testify on Joe Biden's classified docs case as private citizen ... |
| |
|
 | Fani Willis LIVE News | Georgia Senate Committee Probe Alleged Misconduct By Willis... |
| Fani Willis LIVE News, Senate Committee To Probe Alleged Misconduct By Willis, Times Now LIVE. Senate... |
| |
|
 | Why Top Stalwarts Of Congress Are Not Contesting In Election 2024? | Blueprint Explosive... |
| In today's episode of "Blueprint Explosive Exclusive," anchor Padmaja Joshi delves into the discussion... |
| |
|
 | CAA News|We Have Gone Ahead & Given Protection To Those Minorities Who Are Being... |
| Politics erupt for CAA. Mamata Banerjee says that CAA date was chosen before Ramzan. On the other hand.... |
| |
|
 | CAA Big Debate: Muslim Jamaat Lauds Law But IUML Moves SC| Islamic Bodies Divided|... |
| Shortly after the central government notified the rules of the Citizenship Amendment Act, major Muslim... |
| |
|
 | 'In Congress 'Sabki Apni Marzi Chalti Hai' Rasheed Kidwai Hits Out At Opposition... |
| Congress releases second list of 43 candidates for Lok Sabha Elections. Rasheed Kidwai says, "This is... |
| |
|
 | Нападение на Белгородскую область #новости |
| #новости #путин #война #навальный #shorts |
 Штаб Навального Штаб Навального | 36m | |
|
 | Haitian prime minister set to resign |
| Ariel Henry's announcement came after gangs launched an armed rebellion earlier this month. Subscribe... |
| |
|
 | 'All by Myself' singer Eric Carmen dies at 74 |
| Eric Carmen, the singer/songwriter known for hits like "Hungry Eyes," "Almost Paradise," and "All By... |
| |
|
 | Military Strategist Shows How China Would Likely Invade Taiwan | WSJ |
| What was once unthinkable—direct conflict between the United States and China—has now become a commonplace... |
 Wall Street Journal Wall Street Journal | 38m | |
|
 | Localizan a menor reportado como desaparecido dentro de una tienda Target | Noticias... |
| Video oficial de Noticias Telemundo. Los empleados del establecimiento en Ohio localizaron al menor,... |
 NOTICIAS TELEMUNDO NOTICIAS TELEMUNDO | 38m | |
|
| Crece preocupación por brote de sarampión en niños en Estados Unidos | Noticias Telemundo |
| Video oficial de Noticias Telemundo. Luego de que los más recientes casos se reportaran en un albergue... |
 NOTICIAS TELEMUNDO NOTICIAS TELEMUNDO | 38m | |
|
 | Boeing falló 33 de 89 pruebas en la auditoria sobre el proceso de fabricación de... |
| Video oficial de Noticias Telemundo. Según un informe de la inspección que realizó la Agencia Federal... |
 NOTICIAS TELEMUNDO NOTICIAS TELEMUNDO | 38m | |
|
 | Russian spies in Mexico and the US Southern border - GS |
| Search inside imageEntrepreneurial newcomers: Russian-speaking migrant smugglers on the US southern border... |
 The News And Times The News And Times | 39m | |
|
 | Вольфганг Черни – австрийский актёр, сыгравший роли – от немецкого снайпера до Алёши... |
| В российском кинематографе нечасто встречаются иностранные актёры. Но австриец Вольфганг Черни покорил... |
 Комсомольская Правда Комсомольская Правда | 39m | |
|
 | Երեւանում տրանսպորտը թանկացավ. որոշումը կգործի սեպտեմբերից |
| Հետևե՛ք NEWS.am-ին սոցիալական ցանցերում՝ Telegram - https://t.me/newsamarm Facebook - https://www.facebook.com/newsamarm/... |
 NewsamChannel NewsamChannel | 39m | |
|
 | Painting Through Pain | Refuge from K-Pop Cyberbullying | 52 Documentary |
| Solbi, a K-pop icon, encountered intense cyberbullying at the height of her career. In her distress,... |
| |
|
 | Разговор с доктором Леонидом Виленским о медицине в США, республиканцах-демократах,... |
| Долгожданный разговор с нашим большим другом и настоящим доктором Леонидом Виленским, который когда-то... |
 Гулагу-нет Официальный канал Гулагу-нет Официальный канал | 41m | |
|
 | Appeals court to hear oral arguments in Ghislaine Maxwell case | NewsNation Live |
| A U.S. appeals court in New York will hear oral arguments Tuesday in Ghislaine Maxwell's 2021 conviction... |
 NewsNation Now NewsNation Now | 42m | |
|
 | JUST IN: Troy Nehls Reveals What Questions He Will Ask Special Counsel Robert Hur |
| Rep. Troy Nehls (R-TX) discusses Special Counsel Robert Hur's upcoming testimony before the House Judiciary... |
 Forbes Under 30 Forbes Under 30 | 44m | |


